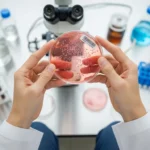
동물세포

에버랜드에서 가장 독특하고 맛있는 길거리 음식은 무엇일까요? 줄 서서 기다릴 만큼 인기 있는 핫도그의 정체는? ‘별난박’이라는 이름부터 범상치 않은 이 간식, 과연 가격은 얼마일까요?
별난박 에버랜드
에버랜드를 자주 가는 사람이라면 ‘별난박’이라는 이름을 한 번쯤 들어봤을 겁니다. 바로 에버랜드에서만 만나볼 수 있는 이색 핫도그 브랜드인데요. 이름처럼 독특한 모양과 맛으로, 많은 방문객의 관심을 끌고 있어요.
별난박은 단순한 먹거리 부스를 넘어서, 에버랜드 내의 명소 중 하나로 자리잡고 있습니다. 무심코 지나칠 수 없는 그 비주얼과 향긋한 냄새는 누구나 한 번쯤 발걸음을 멈추게 만들죠.
에버랜드에서 별난박을 만나야 하는 이유 TOP 7:
-
다채로운 핫도그 종류 – 눈으로도 먹는 즐거움!
-
감성적인 포토존 – 사진 찍기 딱 좋은 비주얼!
-
특유의 바삭함과 쫄깃함 – 밀가루 대신 쌀가루 반죽?
-
달콤 짭조름한 토핑 – 설탕, 체다치즈, 핫치킨 시즈닝 등.
-
SNS 핫플레이스 – 해시태그만 검색해도 수천 개!
-
친절한 직원 응대 – 아이들과 함께 즐기기에도 Good.
-
줄 서는 재미 – 기다릴수록 맛있는 마법?
별난박은 에버랜드 내에서도 특히 유니버설 몬스터 빌리지 근처에 위치해 있어, 어트랙션 사이 잠깐 쉬어가는 코스로도 딱이에요. 처음엔 단순한 간식으로 보일 수 있지만, 이 핫도그 하나에 담긴 정성과 창의성은 여느 미슐랭 음식 못지않습니다.
예를 들어, 한 가족 단위 방문객은 “아이들이 롤러코스터는 무서워했지만, 별난박 핫도그는 너무 좋아해서 두 번 사 먹었다”고 말할 정도였죠. 또 다른 커플은 “사진 찍기 딱 좋은 간식이라서 기억에 남았다”고 후기했어요.
더 많은 정보를 원하시면 아래 버튼을 눌러보세요.
에버랜드 핫도그
에버랜드의 먹거리 중에서도 ‘핫도그’는 늘 상위권에 오르는 인기 메뉴입니다. 하지만 ‘에버랜드 핫도그’ 하면 단순한 소시지에 빵을 입힌 것이 아니라, 창의력 넘치는 플레이버의 향연이 펼쳐져요.
특히 별난박의 핫도그는 기존의 핫도그 틀을 완전히 깨버렸습니다. 이곳에서는 핫도그를 어떻게 만들까?
별난 핫도그의 대표 메뉴 6가지:
-
체다폭탄 핫도그 – 치즈가 넘쳐 흐르는 비주얼.
-
불닭소스 핫도그 – 매운 맛 도전자용!
-
단짠허니 핫도그 – 꿀+버터+소금의 완벽 밸런스.
-
감자크런치 핫도그 – 겉은 바삭, 속은 촉촉.
-
치즈통통 핫도그 – 모짜렐라 치즈를 가득 담은!
-
문어모양 핫도그 – 아이들이 특히 좋아하는 비주얼 메뉴.
단순히 맛뿐 아니라, 보는 즐거움이 함께한다는 것이 에버랜드 핫도그의 가장 큰 특징입니다. 마치 작은 공연처럼, 핫도그가 튀겨지는 과정을 보는 재미도 쏠쏠하죠.
예컨대, 어린 자녀와 함께 방문한 부모들은 “다른 테마파크 음식보다도 더 정성스럽고 위생적으로 느껴졌다”고 평가했고, 외국인 관광객은 “한국식 핫도그는 처음인데 완전 빠져들었다”고 말했어요.
이처럼 핫도그 하나가 에버랜드를 기억하게 만드는 중요한 요소가 되기도 합니다. 혹시 방문하신다면 꼭 놓치지 말고 드셔보시길 추천드립니다.
더 많은 종류의 메뉴가 궁금하다면 아래에서 확인하세요.
에버랜드 별난핫도그 가격
자, 그렇다면 이렇게 특별한 별난핫도그의 가격은 과연 얼마일까요? 많은 분들이 궁금해하는 부분인데요. 결론부터 말하면, 합리적인 가격에 이 모든 퀄리티를 경험할 수 있습니다.
에버랜드 내 별난박 핫도그의 평균 가격은 ₩3,500 ~ ₩5,000 사이입니다. 물론 토핑이나 종류에 따라 약간의 차이는 있지만, 전반적으로는 놀이공원 물가치고 매우 괜찮은 편이에요.
가격대를 결정하는 요소:
-
핫도그 종류 – 클래식 vs 스페셜.
-
토핑 추가 여부 – 치즈, 베이컨 등은 추가 비용 발생.
-
사이즈 옵션 – 미니 vs 라지 핫도그.
-
계절별 한정 메뉴 – 시즌 특가 상품 여부.
-
패키지 구성 – 음료와 세트 구매 시 할인 혜택.
예를 들어, ‘치즈통통 핫도그’는 ₩4,500, ‘불닭소스 핫도그’는 ₩5,000 정도이며, 탄산음료와 세트로 구매하면 ₩7,500 내외로 든든한 간식을 완성할 수 있죠.
특히 평일 오후 시간대에는 대기줄도 짧고, 간혹 프로모션 쿠폰을 이용하면 할인 혜택까지 받을 수 있어요. 많은 리뷰에서 “생각보다 저렴해서 두세 개씩 사 먹었다”는 이야기도 자주 볼 수 있습니다.
또한, 일부 시즌 한정 이벤트에서는 ‘1+1 행사’도 종종 진행되니, 방문 전 미리 홈페이지 또는 SNS를 확인하는 것이 꿀팁이에요.
가격 정보를 실시간으로 확인하고 싶다면 아래 버튼을 눌러주세요.
별난박 에버랜드, 에버랜드 핫도그, 에버랜드 별난핫도그 가격은 단순한 먹거리를 넘어선 에버랜드 경험의 핵심입니다. 눈으로 보고, 코로 맡고, 입으로 즐기고, 카메라에 담을 수 있는 이 핫도그 하나가 주는 즐거움은 상상 이상이에요.
“인생은 짧고, 핫도그는 맛있다.”
– 익명의 먹방 유튜버
에버랜드에 가게 된다면, 핫도그 한 입으로 잊지 못할 하루를 시작해보세요! 🌭✨